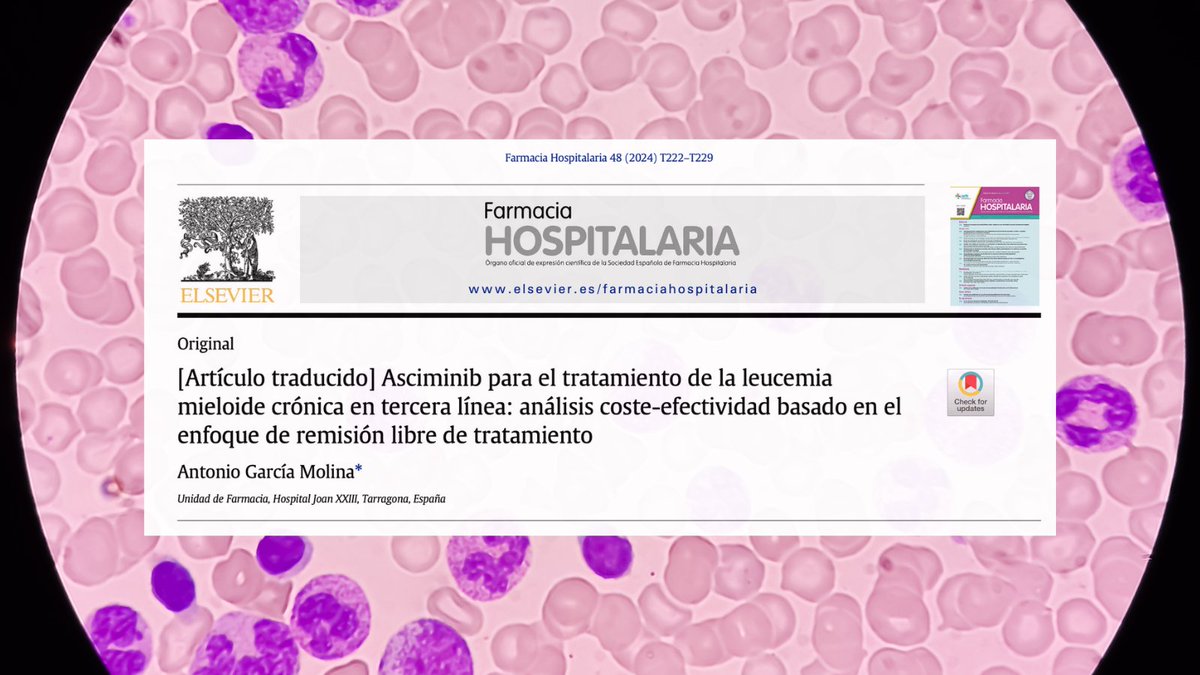
Farmacia Hospitalaria tweet media

FarmaOnco retweetledi

🎨💙 Visual abstract | #RevistaFarmaciaHospitalaria
Plan de acogida en asma grave:
✔️ enfoque centrado en el paciente
✔️ herramientas prácticas
✔️ mejora de experiencia y adherencia
🏥 Más humanización y estandarización
👉 revistafarmaciahospitalaria.es/es-diseno-del-…
#AsmaGrave

Español